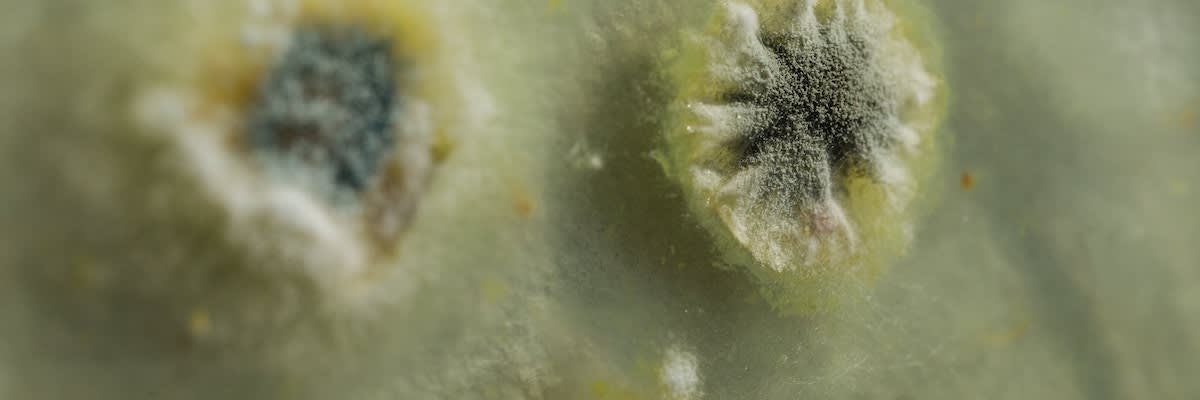

World Microbiome Day is a time to celebrate and share the importance of the microorganisms that live in and on humans, plants, animals, land, and every environment on Earth. These microbes are living creatures that thrive, create, and facilitate the health and wellness of our entire planet, plus they could be the key to unlocking some of the greatest health and ecological challenges existing today.
The World Microbiome: Sustainability
Microbes live in all the environments on Earth, from the soil to the sea, plants, animals, food, and humans, including the most extreme locations on the planet. They provide vital functions and are essential for the survival of ecosystems around the globe, such as the cycling of carbon and other soil nutrients, absorption of gases from the atmosphere into the soil, and decomposition of organic matter to give nutrients to the plants that root there. Microbes also contribute to soil structure and stability with “glues” produced by bacteria and fungi to allow the soil to filter and retain water. Climate change conditions like droughts, extreme weather, temperature, and increased rainfall can disrupt this natural process.
Microbes can even help with future sustainable energy options. Microbial energy conversion technologies harness microorganisms to convert yard waste or crops into ethanol or hydrogen, through the fermentation of sugars and starches into biofuels.1
Microbes are also very handy at protecting plants from pests, diseases, and weeds by directly eliminating them or by making them unable to replicate and spread.
The Human Microbiome: Symbiosis
The human microbiome is a fascinating and intricate ecosystem that exists within and on our bodies, consisting of trillions of microbes (very nearly equal to the number of human cells in our bodies). And while much of medicine is dedicated to combating foreign entities and infections, not all microbes are harmful to our health. In fact, many of them play crucial roles in maintaining our overall well-being. Our bodies are homes for distinct microbiomes in regions like the gut, skin, mouth, and reproductive organs, each with its own unique microbial composition.
The microbiome is an integral part of systems biology, in which the interconnectedness of different systems within our body harmonizes to achieve holistic health. It underscores the significance of understanding that various bodily systems—such as the immune, digestive, cardiovascular, and nervous systems—work together, and focusing on just one system is inadequate to promote optimal health. By nurturing a balanced and diverse microbiome, we can support the interactions between microbes and ourselves as hosts, fostering a comprehensive approach to well-being.
How High is Your “Microbiome IQ?”
Microbiomes exist all over the planet:
Aquatic: Marine, Freshwater, Thermal Springs

Our world’s oceans and freshwater are teeming with microbial life. In fact, 90 percent of the weight of all living things in the ocean is attributed to microbes. They can live in extreme temperatures, from the freezing temperatures of the glacial lakes in the Antarctic to boiling hydrothermal vents.2
Terrestrial: Soil, Peat, Deep Subsurface

While the soil on Earth contains a hugely diverse microbial community (millions of microbes in a single teaspoon!), it is estimated that less than 1 percent of soil microorganisms have been studied in a lab.3 There is still much to uncover about the beneficial applications of soil microbes.
Host-associated: Human, Plants, Mammals, Fungi, Arthropoda (insects, spiders, crustaceans)

Host-associated microbes live in and on their hosts and influence their evolutionary, immune, and ecological processes. Because these entities are “hosts” to their microbiome, they all gather their microbes over time, usually from birth, seedling, hatching, etc. In humans, the microbiome is connected to and influences other systems holistically throughout the entire body, including digestion, energy, sleep, cognition, mood, immune health, oral health, and metabolic health.
Engineered: Wastewater, Lab Enrichment, Solid Waste
One exciting way artificially harnessed microbes can contribute to helping our environment is through bioremediation, a process where microorganisms or plant enzymes are used to detoxify contaminants in water, soil, or other environments.
How many microbiomes are there in the human body?
In and on the human body there are numerous microbiomes including eye, uterus, and bile duct, but there are 6 primary microbiomes that are known and more understood.
Gut Microbiome: The gut microbiome, found in the digestive tract, is one of the most extensively studied human microbial communities, with over 10,000 different species identified. It helps with digestion and nutrient absorption, supports the immune system, and also plays a part in helping regulate mood, skin health, metabolism, hormones, and sleep quality.
Oral Microbiome: The oral cavity contains its own microbiome with approximately 700 different species of bacteria. This microbiome primarily influences oral health including teeth, gums, and breath, as well as saliva composition and oral pH, and acts as a barrier against harmful microbes. It also plays a role in digestion and nutrient absorption, aiding in breaking down food particles. Science is also revealing that the oral microbiome is connected strongly with our overall systemic health, including cardiovascular and cognitive health.
Skin Microbiome: The skin is home to a diverse array of microbes on its surface and within its layers that contribute to skin health and protection against harmful pathogens. This microbiome assists with maintaining a barrier against harmful microbes and infections, pH regulation, inflammatory response, and healthy skin condition regulation.
Respiratory Microbiome: The sinuses, windpipe, and lungs house the respiratory microbiome. Less is known about this microbial community compared to the gut microbiome, but researchers are finding that it has an important role in various functions like immune system interaction and the development of respiratory issues, allergies, and asthma.
Urogenital Microbiome: Grouped together, the urogenital system is the urinary and reproductive organs for both sexes. We separate them out for mention individually.
More is known about the vaginal microbiome at present. It functions to promote a healthy vagina and protect against infections and diseases, pregnancy troubles, and STI acquisition. When the vaginal microbiome is thrown out of balance, this causes an increase in vaginal pH, allowing yeasts and bacteria to populate and create infections (odor, pain, itching, burning, etc.). Specific bacteria need to be abundant in the vagina to promote lactic acid, keeping the local pH low.
Less is known about the male urogenital microbiome. However, recent studies have increased our understanding of urinary tract microbiota and its relevance for men with lower UTI isssues and symptoms.11
Mammary Microbiome: Microorganisms reside in the mammary glands of humans, and although these glands are more developed in females, they do exist in the male body. The mammary microbiome is crucial in helping maintain mammary health and lactation for nursing mothers. Studies suggest microbes may help form the nutrient content of breastmilk for the infant. This is also one of babies’ first exposures to microbes from their mother, including their skin and vaginal microbiome, which helps infants form their own microbiome.
The study of human microbiomes is a rapidly evolving field, and ongoing research may reveal additional microbiomes or refine our understanding.
Time to find out how much you know about microbiomes in you and around the world!
See below for the answers!
Earth:
What percentage of living organisms are found in or associated with soil?
10%
54%
40%
76%
Animal:
What can cows digest that humans can’t, and what is the basic difference in our gut microbiomes that allows this?
Dirt
Cellulose
Dandelions
Corn
Marine:
How much of the world’s oxygen do marine microbes supply?
Around 15%
2%
83%
Half
Plants:
What are the three areas where microbes exist with plants?
Microbes don’t exist on plants
In the air around plants, in the water plants drink, on the bugs that crawl on plants
On the surface of plants, in plant cells, in the soil plants live in
Microbes get sprayed onto plants by humans
Food:
How long have fermented milk products existed on Earth?
About 500 years
2300 years
Over 12,000 years
8000 years
Human:
What are the most prevalent microbial types (or phyla) in the human gut?
Firmicutes and Bacteriodetes
Actinobacteria and Proteobacteria
Fusobacteria and Verrucomicrobia
Answers here!
Earth
The Earth’s soil harbors our main reservoir of biological diversity with 40 percent of creatures living in land-based ecosystems coming into contact with soil during their lifecycles.4 This includes microbial life like fungi, bacteria, archaea, protozoa, and viruses. A single gram of soil may contain several billion bacteria.
Animal
The complex nature of the cow’s four-compartment stomachs and their rumen bacteria allow cows to eat and thrive on plant by-products that humans cannot digest. Cows are able to digest grass, which is made of cellulose, a chain of glucose-like starch. Humans cannot digest cellulose because a specific bond in that starch can’t be broken down in our bodies. Cows have special anaerobic Ruminococcus and Selenomonas bacteria in their gut that humans do not. These species are able to digest cellulose, as they produce cellulase, the enzyme that allows them to break down cellulose.10
Marine
Half of the oxygen in our atmosphere comes from our oceans. While the majority of the O2 comes from oceanic plankton, there are also bacteria that can create oxygen from photosynthesis. One species, Prochlorococcus, is the smallest photosynthetic microbe on the planet, and it produces up to 20 percent of the oxygen in our biosphere. That is more than the oxygen produced by all the tropical rainforests combined.5
Plants
Most plants cannot grow, bloom or survive without microorganisms, and are believed to actively recruit microbes by releasing compounds in the soil that activate the microbes needed by the plant.6 The plant microbiome exists in and on plants in three distinct areas: the leaves and stem the cells or tissue, and the soil around the root system.7
Food
Fermented milk products have existed for over 12,000 years, when humans began fermenting the milk of domesticated camels, goats, sheep, and cattle, probably by accident at first. It’s possible that the first yogurts on earth were created in bags on the backs of camels traveling across the desert in North Africa. Temperatures regularly climbed to 110 degrees Fahrenheit and allowed for the milk to ferment.8
Human
Firmicutes and Bacteriodetes make up 90 percent of the human gut microbiota. While the makeup of human microbiomes are as unique as our fingerprints, these two types of bacteria phyla are the most common in your gut.9
Join in and become a Citizen Scientist!

Find out more about World Microbiome Day here.

What is a Citizen Scientist? Find out more about how to become one by exploring here.

The Human Microbiome Project is ongoing, and studies continue into the microbiome and its interactions with systems biology for total body health.

Learn more about the Earth Microbiome Project and how you can get involved here: Earth Microbiome Project
References:
1 “Microbial Energy Conversion”. (2006). American Society for Microbiology. National Library of Medicine. Ncbi.nlm.nih.gov.
2 Hall, Danielle. (2019). “Marine Microbes”. Ocean - Find Your Blue. Smithsonian. ocean.si.edu.
3 Zhalnina, K., Zengler, K., et al. (2018). “Need for Laboratory Ecosystems to Unravel the Structures and Functions of Soil Microbial Communities Mediated by Chemistry.” mBio, American Society for Microbiology. PubMed Central.
4 State of Knowledge of Soil Biodiversity: Status, challenges and potentialities. Summary for policymakers. (2020). Food and Agriculture Organization of the United Nations.
5 “How much oxygen comes from the ocean?” (n.d). Facts. National Ocean Service, National Oceanic and Atmospheric Administration. Oceanservice.noaa.gov.
6 Pascale, A., Proietti, S., et al. (2019). “Modulation of the Root Microbiome by Plant Molecules: The Basis for Targeted Disease Suppression and Plant Growth Promotion”. Frontiers in Plant Science. PubMed Central.
7 DOE Explains…the Plant Microbiome. (n.d.). Office of Science. Energy.gov.
8 Clime, K. (n.d.). “Beyond Sauerkraut: A Brief History of Fermented Foods”. Living History Farms. Lhf.org.
9 Cohut, M., Ph.D. (2020). [Information on human microbiota]. Medical News Today. medicalnewstoday.com.
10 Aukerman, B., Esselburn, K., et al. (n.d.). Discover the world of Microbes. Microbial Discovery Activity. Bacteria That Help and Hurt Cows. American Society of Microbiology.
11 Kim, M.S., Jung, S.I. (2021). [The urinary microbiome tract in males and lower UTI symptoms]. International Neurology Journal. PubMed Central.